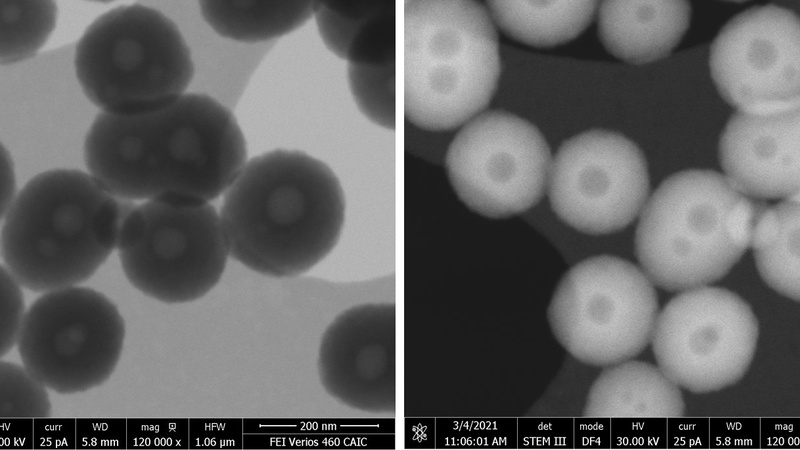
Dopamine NPs

STEM imaging
STEM imaging
The CAIC Verios 460 SEM is equipped with a retractable STEM detector for imaging thin, uncoated samples for Z-contrast imaging. The STEM insert can hold up to 6 samples, often nanoparticles or dry powders, usually applied to TEM holey or lacey carbon film grids. The concentric design of the STEM detector allows to acquire bright-field, various dark-field and HAADF (high-angle annular dark field) images in parallel. Maximum accelerating voltage is 30 keV.
Andrea Bistrovic-Popov, Ljiljana Fruk Group, BioNano Engineering, Department of Chemical Engineering and Biotechnology, University of Cambridge

Nanoparticles with a polydopamine shell and an empty core designed for drug delivery. Melanin is a natural pigment with diverse roles in various organisms. Polydopamine NPs are a synthetic mimic of naturally occurring melanin and are studied for tissue engineering, bioimaging, biosensing, catalysis and drug delivery applications. Pores can be introduced into this material by using templating agents significantly increasing its loading capacity (top: STEM BF and DF4 images, below: SE image of the same material in UC/BD mode).
